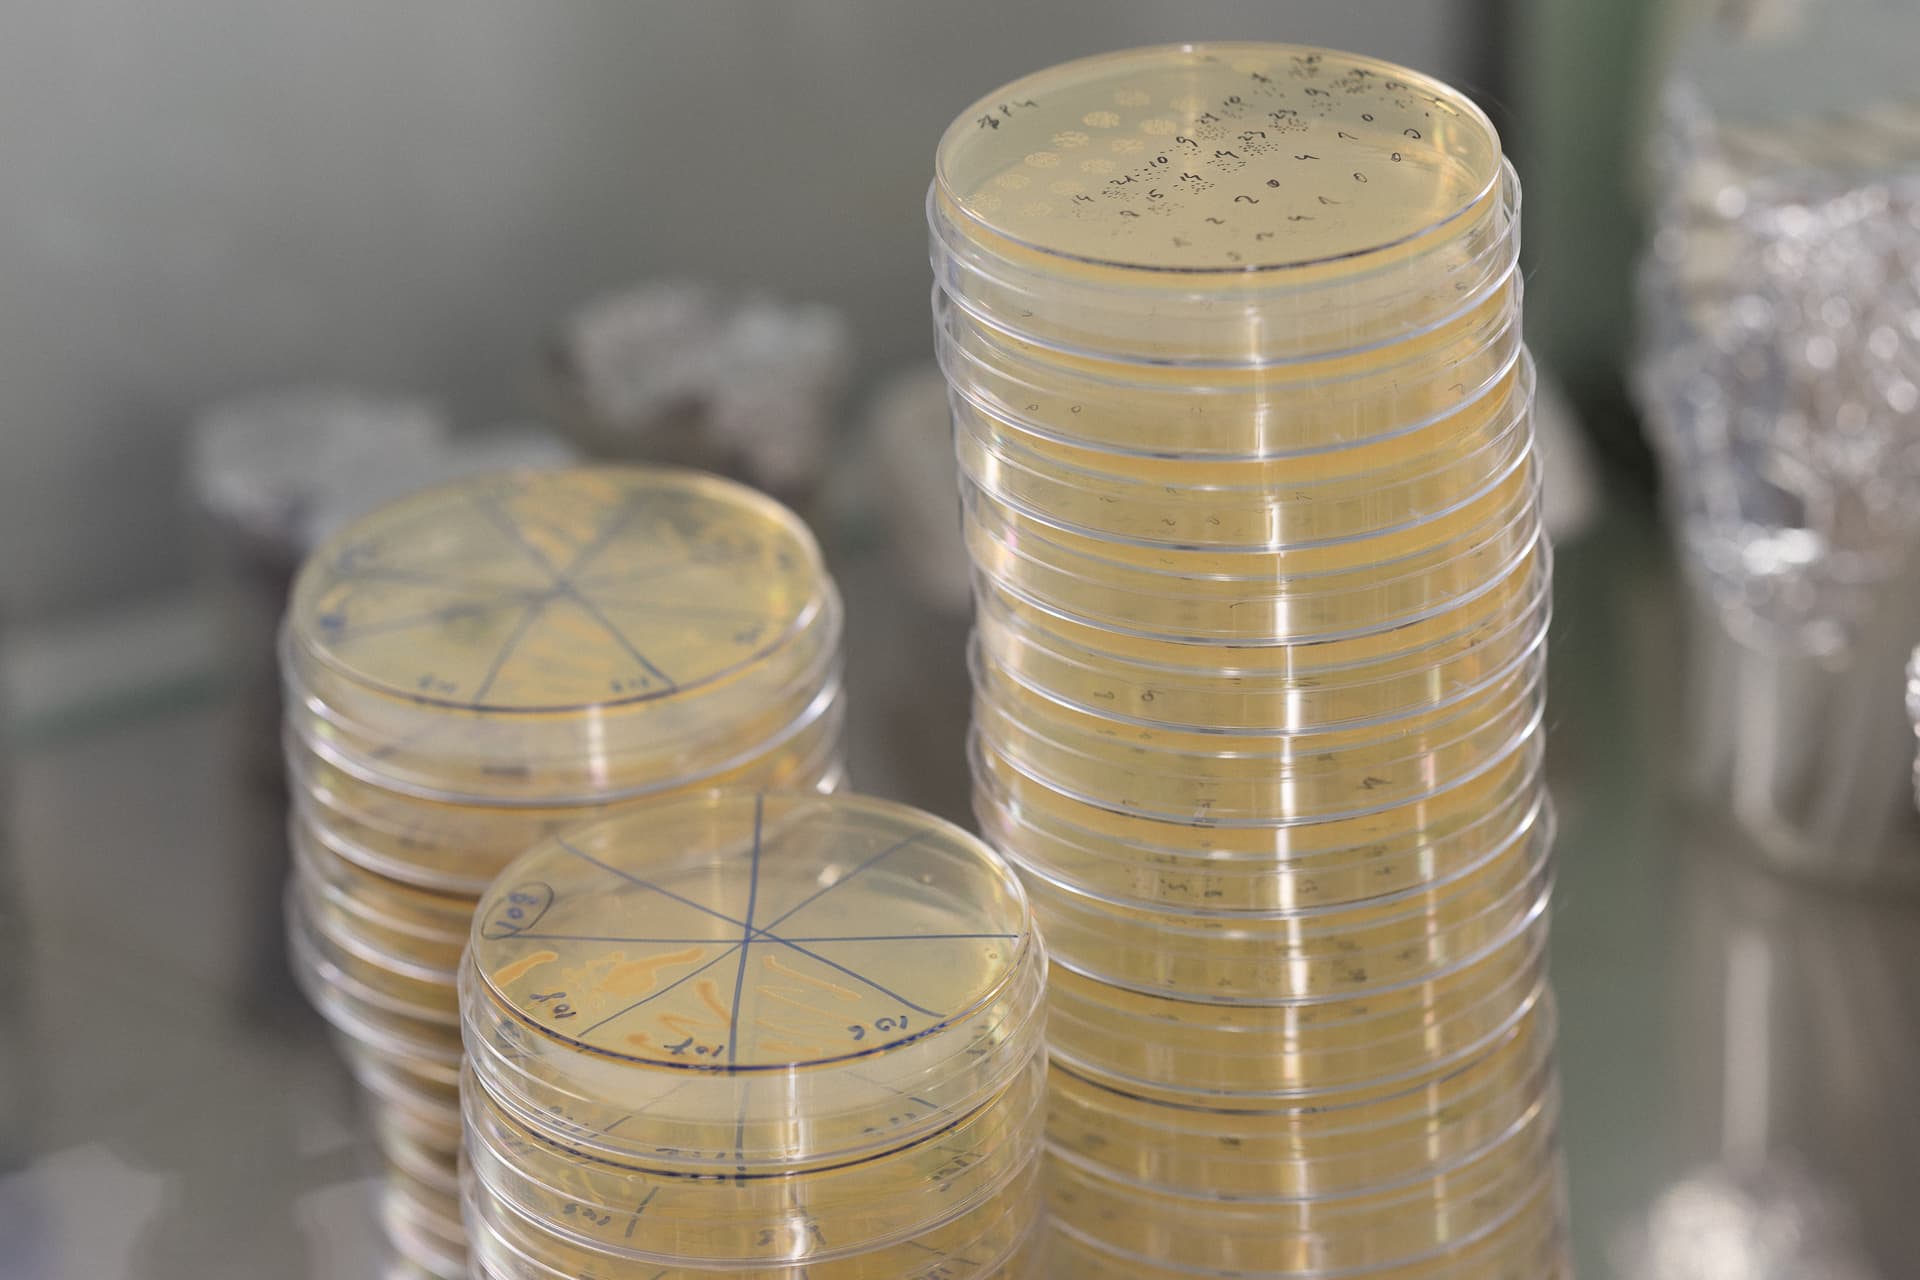
VU_nuotrjpg.jpg

- 2026 m. sausio 8 d. 12:14
Virusinės nanostruktūros – universalus įrankis vakcinoms kurti
Virusinėmis nanostruktūromis paremtos vakcinos yra pranašesnės už įprastas „klasikines“ vakcinas dėl savo saugumo ir itin švelnaus šalutinio poveikio. Nors kol kas tokių patvirtintų vakcinų nėra daug, jas tikimasi panaudoti pasaulyje itin paplitusios ir pavojingos hospitalinės bakterijos Acinetobacter baumannii prevencijai, teigia Vilniaus universiteto Gyvybės mokslų centro mokslininkės doc. Julija Armalytė, dr. Aliona Avižinienė ir dr. Rasa Petraitytė-Burneikienė.
Virusinės nanostruktūros – virusų pavienių baltymų spontaniškai suformuotos erdvinės struktūros. Jas galima išgauti atskirai sintetinant tikrų virusų baltymus, pavyzdžiui, bakterijose, mielėse ar kitose baltymų raiškos sistemose, pasakoja dr. A. Avižinienė.
„Kai susintetinama daug virusinių baltymų, jie spontaniškai vienas su kitu sąveikaudami gali suformuoti erdvines nanostruktūras. Dažniausiai savo morfologija (išvaizda) jos primena natyvų virusą“, – teigia ji.
Mokslininkė pabrėžia, kad virusinė nanostruktūra nėra tolygi virusui, nes nanostruktūroje nėra genetinės viruso medžiagos, todėl į organizmą patekusios tokios nanostruktūros, skirtingai nei virusai, negali sukelti infekcijos ir yra saugios.
„Patekusios į organizmą, jos sukelia imuninį atsaką, nes yra panašios į virusą ir jas sudarantys baltymai tvarkingai pasikartoja struktūros paviršiuje. Nors nemodifikuotos virusinės nanostruktūros gali būti ir jau yra naudojamos vakcinoms kurti, tačiau jų pritaikymas moksle gali būti padidinamas prie nanostruktūrų paviršiaus papildomai prijungiant patogenų baltymus ar jų dalis, prieš kuriuos norima sukurti vakciną. Taigi pavieniai baltymai ar jų dalys, pateikti ant nanostruktūrų paviršiaus, taip pat tampa imunogeniški“, – sako dr. A. Avižinienė.
Pasak dr. R. Petraitytės-Burneikienės, virusinėje nanostruktūroje galima daug kartų pakartoti prie jų prijungtą peptidą.
„Tokie peptidai yra tvarkingai išsidėstę erdvėje tam tikru atstumu, kuris imuninei sistemai palengvina darbą, nes ji yra pratusi prie tvarkingų struktūrų, pavyzdžiui, kaip prieš virusą aktyvuoti savo atsaką“, – tvirtina mokslininkė.
Doc. J. Armalytė pažymi, kad vien patogenų baltymus taip pat būtų galima naudoti kaip vakciną.
„Tačiau uždėjus juos ant viruso imuninė sistema reaguoja geriau. Pavienis baltymas gali būti imuninės sistemos nepastebėtas, o pateiktas ant virusinės nanostruktūros jis geriau atpažįstamas kaip „priešas“. Taip sukuriamas stipresnis imuninis atsakas, negu būtų sukurtas prieš atskirą baltymą“, – sako Gyvybės mokslų centro docentė.
Pranašesnės vakcinos
Pasak dr. A. Avižinienės, virusinėmis nanostruktūromis paremtos vakcinos yra pranašesnės už daug metų naudojamas įprastas vakcinas, nes su pastarosiomis į organizmą suleidžiami inaktyvuoti arba susilpninti virusai.
„Visada išlieka tikimybė, kad ruošiant vakciną virusas bus nevisiškai susilpnintas ar nevisiškai inaktyvuotas. Nors tokios vakcinos yra efektyvios, tačiau nėra visai saugios, nes susilpnintas virusas gali tapti virulentiškas arba vakcinos paruošimo metu viruso cheminis inaktyvinimas gali būti įvykdytas ne iki galo. Tuo tarpu vakcinos, paremtos virusinėmis nanostruktūromis, yra laikomos saugiomis ir efektyviomis“, – sako ji.
Doc. J. Armalytės teigimu, per COVID-19 pandemiją naudotų RNR vakcinų dažnai bijoma, nes su jomis į organizmą patenka genetinė medžiaga. Vis dėlto tikimybė, kad tai galėtų neigiamai paveikti žmogų, yra labai maža. O nanovirusinių struktūrų vakcinose genetinės medžiagos nėra – tik baltymas, kuris niekaip negali paveikti žmogaus genomo.
Dr. R. Petraitytė-Burneikienė sako, kad RNR vakcinos daugumai žmonių sukėlė šalutinių poveikių, pavyzdžiui, karščiavimą. Tuo tarpu baltyminės vakcinos šalutinis poveikis paprastai tėra skausmas dūrio vietoje.
Anot dr. A. Avižinienės, pasaulyje susidomėjimas virusinėmis nanostruktūromis yra didelis, tačiau šiuo metu tokių Pasaulio sveikatos organizacijos patvirtintų vakcinų – vos kelios, įskaitant vakcinas nuo žmogaus papilomos viruso, hepatito B viruso, maliarijos ir Kinijoje naudojamą vakciną nuo hepatito E viruso.
Antibiotikams atsparus patogenas
Vilniaus universiteto Gyvybės mokslų centro mokslininkės vykdo tyrimą, kuriuo bandoma išsiaiškinti, ar virusinėmis nanostruktūromis paremtos vakcinos galėtų apsaugoti nuo bakterijos Acinetobacter baumannii.
Tai – oportunistinis patogenas, puolantis nusilpusią imuninę sistemą turinčius asmenis, sako doc. J. Armalytė. Kartu tai yra ir hospitalinis patogenas, užpuolantis ligoninėje gulinčius žmones. Jis neatsinešamas iš aplinkos, bet juo galima užsikrėsti nuo kateterio, prisilietus prie ligonio paliestų užuolaidų ir pan. Ši bakterija problemiška ir tuo, kad sunkiai „žūsta“ – priešingai nei dauguma kitų bakterijų, A. baumannii labai ilgai neišdžiūsta ore.
Patekusi į nusilpusio žmogaus organizmą, ši bakterija dažniausiai sukelia plaučių uždegimą ir jo komplikacijas ar net sepsį – kraujo užkrėtimą. Patekus į ligoninę dėl vienos priežasties, mirties priežastimi gali tapti A. baumannii bakterija.
„Todėl ji yra ypač pavojinga lėtinėmis ligomis sergantiems žmonėms, kurie atsigula į ligoninę. Šis patogenas yra labai atsparus antibiotikams, o nerandant tinkamų antibiotikų, žmonių su nusilpusia imunine sistema gydymas tampa dar sudėtingesnis. Tokiu atveju alternatyva antibiotikams gali tapti vakcinos“, – sako mokslininkė.
Ji priduria, kad vakcinuoti sergantį ir jau ligoninėje esantį asmenį gali būti sudėtinga. Tačiau jei žmogus žino, kad jam ligoninėje bus atliekamos nuolatinės procedūros, jis galėtų nuspręsti skiepytis iš anksto ir taip apsisaugoti nuo hospitalinių infekcijų.
Lietuvoje bakterija A. baumannii plačiai paplitusi
Dr. A. Avižinienė pažymi, kad 2017 m. Pasaulio sveikatos organizacija įvardijo A. baumannii patogeną kaip vieną pavojingiausių žmogaus sveikatai. O 2019 m. Europos šalyse atliktas tyrimas parodė, kad Lietuva yra tarp septynių šalių, kuriose šios bakterijos paplitimas yra didžiausias ir siekia endeminį lygį.
Doc. J. Armalytės teigimu, sunku pasakyti, kodėl ši bakterija Lietuvoje yra taip plačiai paplitusi. Tai galėjo nulemti nepakankamai griežtai reguliuojamas antibiotikų išdavimas. Kai jie išrašomi be rimtos priežasties ar žmonės nebaigia vartojimo kurso, antibiotikams atsparios bakterijos įsitvirtina kūne, gali įsitvirtinti ir populiacijoje.
„Jei ši bakterija įsitvirtina ligoninėje, gali būti labai sunku ją išnaikinti. Lietuvos medikai į problemą žiūri itin rimtai, stebi A. baumannii plitimą, imasi labai griežtos dezinfekcijos. Tačiau jei ligoninės yra perpildytos, bakterijos plitimo neįmanoma suvaldyti“, – priduria ji.
Mokslininkė tvirtina, kad labai svarbu antibiotikus vartoti atsakingai, pavyzdžiui, negydyti jais gerklės skausmo: „Kol yra tikimybė, kad tai – virusas, antibiotikai visiškai neturi prasmės. Jei žmogus yra sveikas, jis gali sau leisti nevartoti antibiotikų.“
Kuriama vakcina nuo pavojingos bakterijos
Vilniaus universiteto mokslininkės vykdo Lietuvos nacionalinės mokslo programos „Sveikas senėjimas“ tyrimą „Vakcinos prieš hospitalinį patogeną Acinetobacter baumannii kūrimas“, kurio metu bando pagaminti saugią vakciną panaudodamos tam tikrus A. baumannii patogeno baltymus.
Ankstesnių Gyvybės mokslų centro Biomokslų insituto laboratorijoje atliktų tyrimų metu dr. Jūratė Skerniškytė ieškojo įvairių A. baumannii baltymų, lemiančių bakterijos gebėjimą kolonizuoti žmogaus organizmą.
A. baumannii bakterijos. Ginos Beinoravičiūtės nuotr.
„Jūratė rado baltymą adheziną, atsakingą už bakterijos prilipimą prie paviršių. Pasirodo, kad jis yra labai konservatyvus, aptinkamas visose A. baumannii bakterijos variacijose. Kuriant vakcinas naudingi paviršiniai baltymai, kad imuninė sistema greitai atpažintų ir sunaikintų bakteriją. Todėl tyrimams buvo paimtas paviršinio adhezino baltymo fragmentas.
Tyrimų metu dr. J. Skerniškytė nustatė, kad šis fragmentas pelėms suteikia dalinį atsparumą infekcijai – 60 proc. pelių sugebėjo išgyventi. Tačiau tai nėra 100 proc., todėl stengiamės tobulinti šio baltymo gabalėlį: imti įvairius jo fragmentus ir eksponuoti ant virusinių dalelių. Tikimės, kad taip susidarys stipresnis imunitetas ir visos pelės sugebės išgyventi infekciją“, – pasakoja doc. J. Armalytė.
Mokslininkės teigimu, dalis pelių jau buvo imunizuotos ir joms susidarė imunitetas. Preliminarūs tyrimai rodo, kad vakcinacija padeda joms išgyventi infekciją.